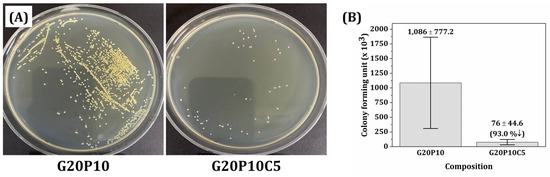

Abstract
We herein demonstrate the utility of gelatin methacryloyl (GelMA)/poly(ethylene glycol) diacrylate (PEGDA)–cerium oxide (CeO2) hydrogel inks for manufacturing hydrogel scaffolds with antimicrobial efficacy by vat photopolymerization. For uniform blending with GelMA/PEGDA hydrogels, CeO2 nanoparticles with a round shape were synthesized by the precipitation method coupled with calculation at 600 °C. In addition, they had highly crystalline phases and the desired chemical structures (oxidation states of Ce3+ and Ce4+) required for outstanding antimicrobial efficacy. A range of GelMA/PEGDA-CeO2 hydrogel scaffolds with different CeO2 contents (0% w/v, 0.1% w/v, 0.5% w/v, 1% w/v, and 5% w/v with respect to distilled water content) were manufactured. The photopolymerization behavior, mechanical properties, and biological properties (swelling and biodegradation behaviors) of hydrogel scaffolds were characterized to optimize the CeO2 content. GelMA/PEGDA-CeO2 hydrogel scaffolds produced with the highest CeO2 content (5% w/v) showed reasonable mechanical properties (compressive strength = 0.56 ± 0.09 MPa and compressive modulus = 0.19 ± 0.03 MPa), a high swelling ratio (1063.3 ± 10.9%), and the desired biodegradation rate (remaining weight after 28 days = 39.6 ± 2.3%). Furthermore, they showed outstanding antimicrobial efficacy (the number of colony-forming units = 76 ± 44.6 (×103)). In addition, macroporous GelMA/PEGDA-CeO2 hydrogel scaffolds with tightly controlled porous structures could be manufactured by vat photopolymerization.
1. Introduction
Hydrogels have gained significant attention in tissue engineering due to their ability to mimic the extracellular matrix (ECM) of natural tissues when implanted into the human body [1,2,3,4,5]. In particular, they are comprised of a 3D network of semi-permeable, hydrophilic polymer chains, thus enabling them to absorb a large amount of water. This unique feature can provide favorable environments for the transport of body fluids, including blood, oxygen, nutrients, and growth factors essential to tissue regeneration [1,2]. In addition, hydrogels can offer high flexibility and mechanical properties similar to those of natural tissues [6,7]. Thus, they can be used for regenerating not only hard (e.g., bones) tissues but also soft (e.g., cartilages, skins, and nerves) tissues [3,4,5,8,9,10,11,12].
Among hydrogels, gelatin methacryloyl (GelMA) has demonstrated great promise since it can provide desired biological and mechanical functions when implanted into the human body, along with easy formulation into scaffolds [3,4,8,9,13,14,15,16,17]. More specifically, GelMA is a derivative of natural gelatin, thus offering biocompatible surfaces and sites for cell adhesion, which is one of the most crucial steps for new tissue formation, and reasonable biodegradability via enzymatic cleavage [3,4]. In addition, GelMA can be readily formulated into gel-like solids (hydrogels) through photo-crosslinking of methacrylamide and methacrylate side groups introduced by the modification of gelatin with methacrylic anhydride [3,4]. Thus, arbitrarily designed external and internal geometries specially designed for target tissues can be constructed using 3D printing techniques [13,14,15,16,17,18,19,20,21,22,23,24]. For example, three-dimensionally interconnected macroporous structures can facilitate new tissue formation by providing 3D pores for cell migration and large surfaces for cell adhesion, proliferation, and differentiation [16,18,19,20,21,22]. In addition, tubular and multichannelled structures can effectively guide nerve regeneration through unidirectionally aligned channels [23,24]. To this end, material extrusion (ME)- and vat photopolymerization (VP)-based 3D printing techniques have been widely utilized. The ME-based 3D printing technique can dispense GelMA-based solutions (inks) through fine nozzles and then deposit extruded filaments according to predetermined build paths with the assistance of photo-crosslinking for good shape retention [18,19,20]. However, this technique has limited dimensional accuracy owing to its material extrusion approach. On the other hand, the VP-based 3D printing technique can selectively photopolymerize thin layers of GelMA-based inks, for example, using high-resolution digital light processing (DLP) engines, thus allowing the construction of more sophisticated porous structures with high dimensionally accuracy [21,22,23,24].
To widen the clinical uses of GelMA-based hydrogel scaffolds, GelMA can be hybridized with other synthetic hydrogels, in order to enhance and/or tailor its mechanical properties and biological functions [20,22,23,24,25,26,27,28]. In particular, when hybridized with poly(ethylene glycol) diacrylate (PEGDA), a kind of PEG-derived synthetic hydrogel [5,10,11,29,30], the mechanical properties and biological functions (e.g., swelling and biodegradation behaviors) of GelMA/PEGDA hydrogel scaffolds can be enhanced and/or tailored by adjusting the GelMA/PEGDA ratio [20,22,23,24,26,27,28]. They can also be formulated into macroporous structures using the VP-based 3D printing technique [22,23,24]. Furthermore, to prevent infections and reduce postoperative complications, antimicrobial and antibacterial inorganic fillers can be incorporated into GelMA-based hydrogels, which can eradicate bacteria when implanted in the human body [31]. To this end, a variety of nanomaterials, including silver nanoparticles (AgNPs) [32,33,34], graphene oxide [35,36], zinc oxide (ZnO) [37,38], and cerium oxide (CeO2) [39,40], have been examined. In particular, cerium oxide can offer additional advantageous functions, especially for wound healing applications [41,42,43,44,45]. More specifically, its anti-inflammatory and antioxidant properties can remarkably reduce inflammatory responses and oxidative stress caused by excessive reactive oxygen species (ROS), respectively, thus alleviating damage to wound tissue. In addition, its angiogenesis property can facilitate the formation of new blood vessels from pre-existing vessels, which can accelerate wound healing by supplying oxygen and nutrients to the cells involved in tissue repair.
Thus, the main purpose of this study is to demonstrate the manufacturing of CeO2-incorporated GelMA/PEGDA hydrogel composite scaffolds with antimicrobial efficacy using VP-based 3D printing. In particular, to obtain homogeneous inks for VP-based 3D printing, several processing parameters were carefully controlled and optimized, including synthesis of CeO2 nanoparticles, sequence and temperature for blending of CeO2 solutions with PEGDA and GelMA solutions, inert dye content, and photo-crosslinking time. To optimize the CeO2 content, a range of GelMA/PEGDA-CeO2 inks with different CeO2 contents (0% w/v, 0.1% w/v, 0.5% w/v, 1% w/v, and 5% w/v with respect to distilled water content) and their rheological and photo-crosslinking behaviors were examined. The mechanical properties of printed hydrogels were examined by compressive strength tests. Their biological properties, including swelling behavior, biodegradation behavior, and antimicrobial efficacy, were examined.
2. Materials and Methods
2.1. Synthesis of CeO2 Nanoparticles
A schematic diagram showing the manufacturing of CeO2-incorporated GelMA/PEGDA hydrogel scaffolds by VP-based 3D printing using the photo-crosslinking process is shown in Figure 1. Cerium oxide nanoparticles were synthesized by slightly modifying the precipitation method reported in the literature [46,47]. Briefly, 10.0 g of cerium nitrate hexahydrate (Ce(NO3)3·6H2O; 22.4 mmol, 1.0 eq.) supplied by Sigma Aldrich (Saint Louis, MO, USA) was completely dissolved in 115.0 cm3 of distilled water at 60 °C for 30 min by magnetic stirring. After which, 10.75 g of ammonia water (NH4OH (30%; 189.0 mmol, 8.4 eq.) supplied by Daejung Chemicals (Siheung-si, Gyeonggi-do, Republic of Korea) was added dropwise into the solution during magnetic stirring for 2 h, then cooled down to room temperature. Finally, the mixture was stirred for 24 h at room temperature to ensure a complete chemical reaction between reactants. Solid precipitates (Ce(OH)4·H2O) obtained were washed three times with distilled water and acetone in sequence, and then filtered. Precipitates were dried in a furnace (Ajeon Heating Industrial Co., Ltd., Namyangju-si, Gyeonggi-do, Republic of Korea) at 120 °C for 4 h, and then calcined at 600 °C for 2 h to obtain CeO2 nanoparticles.

Figure 1.
Schematic diagram showing the manufacturing of CeO2-incorporated GelMA/PEGDA hydrogel scaffolds by VP-based 3D printing using photo-crosslinking process.
2.2. Characterization of CeO2 Nanoparticles
The morphologies of synthesized CeO2 nanoparticles were examined using field emission scanning electron microscopy (FE-SEM; JSM-6701F, JEOL Techniques, Tokyo, Japan). Their crystalline structures and phases were analyzed by X-ray diffraction (P-XRD, Ultima III, Rigaku, Japan). X-ray photoelectron spectroscopy (XPS, X-Tool, Ulvac-Phi, Inc., Kanagawa, Japan) was also used to analyze the chemical compositions and oxidation states of CeO2 nanoparticles.
2.3. Preparation of GelMA/PEGDA-CeO2 Hydrogel Inks
GelMA was kindly supplied by KD Research Center (KD Research Center, Busan, Republic of Korea) and PEGDA monomer (Mn 575, Sigma Aldrich, Saint Louis, MO, USA) was used as received. A range of GelMA/PEGDA-CeO2 hydrogel inks with different CeO2 contents (0% w/v, 0.1% w/v, 0.5% w/v, 1% w/v, and 5% w/v with respect to distilled water content) were prepared (Table 1). The GelMA/PEGDA ratio was determined by considering our previous work [23] and preliminary tests. In addition, BYK-190 (BYK-Chemie Inc., Kempen, Germany) was used as the dispersant. As the photoinitiator, lithium phenyl (2,4,6-trimethylbenzoyl) phosphinate (LAP; Sigma Aldrich, Saint Louis, MO, USA) was employed particularly due to its low cytotoxicity and active wavelength for VP-based 3D printing [16]. The chemical structure of LAP and its working mechanism for the photo-crosslinking of GelMA/PEGDA hybrid hydrogels is shown in Figure 1. When excited by UV light (e.g., 405 nm), LAP can undergo cleavage and generate free radicals, which can initiate photo-crosslinking of photocurable side groups of GelMA and PEGDA, resulting in gel-like solids (hydrogels) tough chain propagation. Allura Red dye (Sigma Aldrich, Saint Louis, MO, USA) was used as the inert dye. To this end, predetermined amounts of CeO2 nanoparticle, dispersant, and inert dye were added into bottles containing zirconia balls used as the grinding and mixing medium. Distilled water was then added into mixtures and vigorously mixed by a planetary mixer (Hantech Co, Ltd., Hwaseong-si, Gyeonggi-do, Republic of Korea) for 30 min at 1000 rpm. After which, CeO2 suspensions obtained were sieved to remove the zirconia balls and transferred into glass beakers. CeO2 suspensions were placed at 60 °C to homogenously blend them with PEGDA and GelMA. Predetermined amounts of PEGDA monomers were added into CeO2 suspensions and mixed by magnetic stirring at 400 rpm for 1 h. After which, predetermined amounts of GelMA powders were gradually added into blends to ensure fast, complete dissolution. For VP-based 3D printing, the photoinitiator was added into GelMA/PEGDA-CeO2 hydrogel inks.

Table 1.
Components used to prepare GelMA/PEGDA-CeO2 hydrogel inks for vat photopolymerization and their fractions (% w/v) calculated by considering the volume of distilled water used as the solvent for GelMA.
2.4. Photopolymerization Behaviors of GelMA/PEGDA-CeO2 Hydrogel Inks
To examine the utility of various GelMA/PEGDA-CeO2 hydrogel inks (CeO2 contents = 0% w/v, 0.1% w/v, 0.5% w/v, 1% w/v, and 5% w/v) for vat photopolymerization, their photopolymerization behaviors were evaluated using a photo-differential scanning calorimeter (Photo-DSC) (DSC4000; Perkin Elmer, Waltham, MA, USA). To this end, various hydrogel inks with different CeO2 contents (0% w/v, 0.1% w/v, 0.5% w/v, 1% w/v, and 5% w/v) were illuminated by UV light with a power of 20 mW/cm2 for 2 min. Heat flows generated by photopolymerization were monitored as a function of time and then used to compute the percent conversions of the hydrogel inks [48].
In addition, to utilize our custom-built VP printer (Veltz3D, Incheon, Republic of Korea) for manufacturing hydrogel scaffolds, the photopolymerization behaviors of various hydrogel inks (CeO2 contents = 0% w/v, 0.1% w/v, 0.5% w/v, 1% w/v, and 5% w/v) were characterized. Warm hydrogel inks prepared at 60 °C were uniformly spread onto build platforms using a specially designed recoater (Figure 2) and then photopolymerized for 3 s using a digital light processing (DLP) engine illuminating UV light with a power of ~13.6 mW/cm2 at a peak wavelength of ~405 nm. After which, photopolymerized layers were carefully removed and their thicknesses were measured using a micrometer.

Figure 2.
Schematic diagram of the DLP 3D printing technique with GelMA-based hydrogel.
2.5. Vat Photopolymerization of GelMA/PEGDA-CeO2 Hydrogel Scaffolds
Several different types of GelMA/PEGDA-CeO2 hydrogel scaffolds (CeO2 contents = 0% w/v, 0.1% w/v, 0.5% w/v, 1% w/v, and 5% w/v) were manufactured using our custom-built VP printer. To evaluate the microstructures (e.g., hybridization behavior of GelMA/PEGDA with CeO2 nanoparticles), mechanical properties, and biological properties of hydrogel scaffolds, bulk samples without a 3D macroporous structure were manufactured using a layer thickness of 100 μm and UV illumination time of 3 s. In addition, as the model, 3D macroporous hydrogel scaffolds with a honeycomb-like structure were manufactured using the highest CeO2 content of 5% w/v.
2.6. Microstructure and Mechanical Properties of GelMA/PEGDA-CeO2 Hydrogel Scaffolds
The microstructures of various GelMA/PEGDA-CeO2 hydrogel scaffolds (CeO2 contents = 0% w/v and 5% w/v) were examined by FE-SEM. For these observations, samples were freeze dried to remove ice crystals formed via freezing of water. Their surfaces were then coated with gold using a magnetron sputter coater (108Auto, Cressington, UK) at 20 mA for 120 s under high vacuum, and then, FE-SEM images were taken at an acceleration voltage of 10 kV with a working distance of 8 mm. In addition, BSE (backscattered electron) images were taken during FE-SEM operations, in order to clarify the distribution of CeO2 nanoparticles in GelMA/PEGDA hybrids.
The mechanical properties of various GelMA/PEGDA-CeO2 hydrogel scaffolds (CeO2 contents = 0% w/v, 1% w/v, and 5% w/v) were evaluated by compressive strength tests using a universal testing machine (UTM; ST-1000, Salt Co., Ltd., Incheon, Republic of Korea). Cylindrical samples with a diameter of 12 mm and a height of 5 mm were compressed at a constant cross-head speed of 1 mm/min. Their compressive stresses as a function of strain were monitored, and were used to compute their compressive strengths and moduli. Five specimens for each composition were tested to assess the mean value and standard deviation.
2.7. Biological Properties of GelMA/PEGDA-CeO2 Hydrogel Scaffolds
The swelling behaviors, biodegradation behaviors, and antimicrobial efficacy of various GelMA/PEGDA-CeO2 hydrogel scaffolds (CeO2 contents = 0% w/v, 0.1% w/v, 0.5% w/v, 1% w/v, and 5% w/v) were examined. To this end, five cylindrical samples (12 mm in diameter and 5 mm in height) were manufactured for each composition.
For swelling tests, samples were immersed in phosphate-buffered saline (PBS) solutions (Sigma Aldrich, Saint Louis, MO, USA) at 37 °C for 3 days. The weights of swollen samples (Ws) were measured by an electronic balance. After which, the swollen samples were fully freeze dried for 7 days, and their weights (Wd) were measured. The swelling ratios of the hydrogel scaffolds were then computed, as follows:
Swelling ratio (%) = (Ws − Wd)/Wd × 100
For biodegradation tests, samples fully swollen after immersion in a PBS solution for 3 days at 37 °C were soaked in collagenase solutions with a concentration of 10 mg/L (Sigma Aldrich, Saint Louis, MO, USA) up to 28 days. The weights of the samples (Wb) were measured periodically with a time interval of 7 days. The biodegradability of samples was then computed as follows:
Biodegradability (%) = (Ws − Wb)/Ws × 100
To assess the antimicrobial efficacy of CeO2 nanoparticles, GelMA/PEGDA-CeO2 hybrid scaffolds and GelMA/PEGDA-CeO2 hybrid scaffolds without CeO2 (0% w/v) and with the highest CeO2 content of 5% w/v were tested. As the model, S. mutans (NCTC 10449) cultured in Luria–Bertani broth (LB; BD Biosciences, Franklin Lakes, NJ, USA) were employed. In total, 1 mL of a bacterial suspension (1.1 × 106 CFU/mL) was added to samples placed in 24-well plates and then incubated for 24 h. After which, the samples were gently washed four times with a phosphate-buffered saline solution (PBS; Thermo Fisher Scientific Inc., Waltham, MA, USA) to remove all the non-adherent bacteria. The attached bacteria were then harvested in a 3 mL Dulbecco’s phosphate-buffered saline (DPBS; Welgene, Gyeongsan-si, Gyeongsangbuk-do, Republic of Korea) solution by vortexing for 1 min. Then, 100 μL of harvested bacterial suspension for each composition was spread onto a solid agar plate and incubated for 24 h at 37 °C, and the total number of colonies were counted by ImageJ (Version 1.54g, U. S. National Institutes of Health, Bethesda, MD, USA).
2.8. Statistical Analysis
Before performing all parametric statistics, the normality of distributions was verified with the Shapiro–Wilk test. All data were expressed as the mean ± standard deviation. Statistical analysis was performed using a one-way analysis of variance (ANOVA) with Tukey’s post-hoc test using MATLAB (Release 2024b, The MathWorks, Inc., Natick, MA, USA). A p-value < 0.05 was considered statistically significant, which was graphically demonstrated with different superscripts within each figure.
3. Results
3.1. Characteristics of CeO2 Nanoparticles
To optimize the use of CeO2 as an antimicrobial agent in GelMA/PEGDA hydrogel scaffolds, CeO2 nanoparticles with specific physical and chemical characteristics were synthesized using the precipitation method reported in the literature [46,47]. However, we herein employed a relatively low temperature (600 °C) for calcination to avoid strong agglomeration between primary particles. Subsequently, the morphologies, crystalline phases, and chemical structures of the synthesized CeO2 nanoparticles were thoroughly characterized using various analytical tools.
The morphologies of synthesized CeO2 nanoparticles were examined by FE-SEM, and their representative FE-SEM images are shown in Figure 3. All primary particles showed a round shape with very small sizes in the range of ~80 nm–120 nm roughly estimated from the FE-SEM images. This is one of the most striking advantageous features of the precipitation method that can utilize a chemical reaction between ions dissolved in liquid mediums. Although the primary particles were partially bonded (Figure 3B), they were subsequently dispersed into nanoparticles during the preparation of CeO2 suspensions through a vigorous planetary mixing process.

Figure 3.
Representative FE-SEM images of synthesized CeO2 nanoparticles (A) at low and (B) at high magnifications.
The crystalline phases of synthesized CeO2 nanoparticles were characterized by XRD, as shown in Figure 4A. A number of strong, sharp peaks were observed, suggesting that CeO2 nanoparticles could be highly crystallized after calcination even at a relatively low temperature of 600 °C. In addition, all peaks are well matched to those of CeO2 with a cubic fluorite structure (JCPDS card # 01-081-0792). No secondary phases were observed, indicating the high purity of synthesized CeO2 nanoparticles. Fundamentally, the antimicrobial efficacy of CeO2 is strongly affected by its oxidation states, often described as the Ce3+/Ce4+ ratio [43,44,49]. Thus, XPS was employed to clarify the oxidation states of Ce3+ and Ce4+, as shown in Figure 4B. Bind energies of 880.8 eV, 885.6 eV, and 903.9 eV are the binding energies of the Ce3+ oxidation state, and the other peaks correspond to the Ce4+ oxidation state. Note that the Ce3+ oxidation state of cerium oxide is well known to have anti-oxidation, anti-inflammatory, and anti-apoptosis abilities, and the extraordinary biological characteristics of cerium oxide due to the reduction of Ce4+ to Ce3+ [50,51,52].

Figure 4.
(A) XRD pattern and (B) XPS spectrum of synthesized CeO2 nanoparticles.
3.2. Photopolymerization Behavior of GelMA/PEGDA-CeO2 Hydrogel Inks
To fabricate GelMA/PEGDA-CeO2 hydrogel scaffolds with the high CeO2 contents necessary for effective antimicrobial functions, hydrogel inks should be efficiently photopolymerized using UV light powers compatible with VP printers. Thus, the influence of CeO2 addition on the photopolymerization behaviors of GelMA/PEGDA hydrogels was examined by photo-DSC, as shown in Figure 5A. All hydrogel inks showed one exothermic peak associated with photopolymerization of both GelMA and PEGDA (Figure 5A). However, the total enthalpy decreased with an increase in CeO2 content—16.7 J/g, 14.9 J/g, 14.4 J/g, 12.2 J/g, and 6.0 J/g for CeO2 contents of 0% w/v, 0.1% w/v, 0.5% w/v, 1% w/v, and 5% w/v, respectively. This trend can be attributed to the UV light scattering by CeO2 nanoparticles, which impedes the photopolymerization of GelMA/PEGDA hybrids. However, it should be noted that this concern would be mitigated by employing the thin layers of hybrid inks for layer-by-layer VP processes. In addition, all hybrid inks can be photopolymerized significantly within a reasonable period of time (~40 s), which would be applicable to conventional UV light engines used for VP printers.

Figure 5.
(A) Photo-DSC results and (B) cure depths obtained at 60 °C as a function of exposure time for photopolymerization from various GelMA/PEGDA-CeO2 hydrogel inks (CeO2 contents = 0% w/v, 0.1% w/v, 0.5% w/v, 1% w/v, and 5% w/v).
To achieve strong interlayer bonding and high dimensional accuracy, optimization of UV exposure time is crucial for specific layer thicknesses, such as the 100 μm utilized in this study. To this end, the layers of various GelMA/PEGDA-CeO2 hydrogel inks (CeO2 contents = 0% w/v, 0.1% w/v, 0.5% w/v, 1% w/v, and 5% w/v) were photopolymerized using our custom-built VP printer. The cure depth defined by the thickness of the photopolymerized layer decreased with an increase in CeO2 content (Figure 5B), as expected from the photo-DSC results. However, the GelMA/PEGDA-CeO2 hydrogel with 0.1% w/v CeO2 content showed a higher cure depth than the GeIMA/PEGDA hydrogel. It is supposed that a small amount of CeO2 nanoparticles would slightly scatter UV light to local positions, thus resulting in thicker polymerized layers.
3.3. Microstructures of GelMA/PEGDA-CeO2 Hydrogel Scaffolds
To examine the utility of CeO2 nanoparticles synthesized in this study for blending with GelMA/PEGDA hydrogels, the microstructures of various GelMA/PEGDA-CeO2 hydrogel scaffolds manufactured by our custom-built VP printer were examined by FE-SEM. For these observations, hydrogel scaffolds were freeze dried to remove water. Figure 6A,B show the representative FE-SEM images of GelMA/PEGDA-CeO2 hydrogel scaffolds with different CeO2 contents (0% w/v and 5% w/v) for comparison purposes. Without CeO2 nanoparticles, the GelMA/PEGDA hybrid scaffold showed a highly porous structure comprised of relative dense GelMA/PEGDA frameworks (Figure 6A), where pores were created as the replica of ice crystals. To more clearly assess the distribution of CeO2 nanoparticles within GelMA/PEGDA frameworks, a BSE image was taken from the hydrogel scaffold with the highest CeO2 content (5% w/v) during FE-SEM operations (Figure 6B). It was observed that a number of CeO2 nanoparticles, appearing in the bright contrast, were uniformly distributed in GelMA/PEGDA frameworks.

Figure 6.
Representative FE-SEM images of GelMA/PEGDA-CeO2 hydrogel inks with various CeO2 contents of (A) 0% w/v, and (B) 5% w/v, where white contrast represents CeO2 nanoparticles. The yellow arrows indicate GelMA/PEGDA frameworks, and the inside marked by dashed line corresponds to pores.
It should be noted that as-manufactured hydrogel scaffolds can contain a large amount of water used as the solvent for GelMA powders. Thus, during freeze drying of hydrogel scaffolds required for FE-SEM observations, large ice crystals can be formed via the freezing of water and then sublimed, resulting in large pores. In addition, in the case of the BSE image (Figure 6B), it is reasonable to suppose that the yellow arrows indicate GelMA/PEGDA frameworks, and thus, the insides marked by dashed lines can be considered to be pores formed as the replica of ice crystals. This observation suggests that CeO2 nanoparticles can hinder the growth of ice crystals during freezing, thus resulting in a smaller pore size and slightly lower porosity. However, it should be noted that these pores can allow the transport of water, and thus, dried GelMA/PEGDA frameworks can reabsorb considerable amounts of water.
3.4. Mechanical Properties of GelMA/PEGDA-CeO2 Hydrogels
To assess the structural stabilities of various GelMA/PEGDA-CeO2 hydrogel inks during tissue regeneration, the mechanical properties of various hydrogels were evaluated by compressive stress tests [53]. Note that GelMA/PEGDA and GelMA/PEGDA-CeO2 with high CeO2 contents (1% w/v and 5% w/v) were tested to clarify the influence of CeO2 on compressive strength. The representative compressive stresses as a function of strain are demonstrated in Figure 7A. All hydrogel scaffolds showed that stress increased almost linearly with an increase in strain and then dropped due to the eruption of water trapped. The compressive strengths and moduli of various hydrogel scaffolds computed from their stress–strain curves are demonstrated in Figure 7B. As the CeO2 content increased, the compressive strengths and moduli decreased. These reductions would presumably be due to the fact that interfaces between CeO2 nanoparticles and GelMA/PEGDA would act as crack origins during compression tests. However, if required, the mechanical properties of GelMA/PEGDA-CeO2 hydrogel scaffolds would be enhanced by creating strong interfacial bonding, for example, through surface modification of CeO2 nanoparticles with agents’ high affinity to GelMA/PEGDA hydrogels. It should be noted that GelMA/PEGDA-CeO2 hydrogel scaffolds with the highest CeO2 content (5% w/v) can provide reasonably high compressive strengths (0.56 ± 0.09 MPa) and moduli (0.19 ± 0.03 MPa) for soft tissue regeneration (e.g., wound healing) [54,55].

Figure 7.
(A) Representative compressive stress–strain curves and (B) compressive strengths and moduli of various GelMA/PEGDA-CeO2 hydrogel inks (CeO2 contents = 0% w/v, 1% w/v, and 5% w/v). Different letters in each color represent statistical significance (p-value < 0.05).
3.5. Swelling and Biodegradation Behaviors of GelMA/PEGDA-CeO2 Hydrogel Scaffolds
To assess the structural integrity of GelMA/PEGDA-CeO2 hydrogel scaffolds, their swelling and biodegradation behaviors were examined. The swelling behaviors of various hydrogel scaffolds (CeO2 contents = 0.1% w/v, 0.5% w/v, 1% w/v, and 5% w/v) were examined by measuring their water absorption capabilities in PBS solutions. When the relatively low CeO2 contents were used, all hydrogel scaffolds showed similar swelling ratios—499.3 ± 12.7%, 492.9 ± 2.6%, and 494.7 ± 3.5% for CeO2 contents of 0.1% w/v, 0.5% w/v, and 1% w/v, respectively (Figure 8). This finding suggests that the GelMA/PEGDA hydrogel networks produced by our VP printer are permeable, thus absorbing a considerable amount of body fluids when implanted into the human body. However, the hybrid scaffolds with the highest CeO2 content (5% w/v) showed much higher swelling ratios (1063.3 ± 10.9%) than other scaffolds. This lies in the fact that CeO2 nanoparticles would hinder the crosslinking of GelMA/PEGDA hydrogel networks during photopolymerization by our VP printer, thus offering the higher water absorption capability.

Figure 8.
Swelling ratios of various GelMA/PEGDA-CeO2 hydrogel scaffolds (CeO2 contents = 0.1% w/v, 0.5% w/v, 1% w/v, and 5% w/v). Same letters (a) represent no statistical significance (p-value > 0.05).
The biodegradation behaviors of various hydrogel scaffolds were examined by measuring their mass losses in PBS-collagenase solutions (Figure 9A). The hybrid scaffolds with relatively low CeO2 contents showed similar weights remaining—54.5 ± 1.6%, 60.0 ± 2.4%, and 57.2 ± 2.5% for CeO2 contents of 0.1% w/v, 0.5% w/v, and 1% w/v, respectively (Figure 9B). On the other hand, when the highest CeO2 content (5% w/v) was used, notably lower remaining weights (39.6 ± 2.3%) were observed simply due to a reduction in the fraction of biodegradable GelMA/PEGDA hydrogel networks.

Figure 9.
(A) Remaining weights of various GelMA/PEGDA-CeO2 hydrogel scaffolds (CeO2 contents = 0.1% w/v, 0.5% w/v, 1% w/v, and 5% w/v) during biodegradation in PBS-collagenase solutions as a function of time and (B) remaining weights after 28 days. Different letters represent statistical significance (p-value < 0.05).
3.6. Antimicrobial Efficacy of GelMA/PEGDA-CeO2 Hydrogel Scaffolds
For clinical uses for wound healing, hydrogel scaffolds are preferred to have antimicrobial efficacy to avoid the use of additional antibiotics [56]. By considering the mechanical properties, swelling behavior, and biodegradation behavior of GelMA/PEGDA-CeO2 hydrogel scaffolds, the highest CeO2 content of 5% w/v was employed for evaluating antimicrobial efficacy. For comparison purposes, the GelMA/PEGDA hydrogel scaffold without CeO2 addition was also tested. It was observed that the number of S. mutans used as the model bacterium decreased remarkably with CeO2 addition (Figure 10A). The numbers of colony-forming units were 1086 ± 777 (×103) and 76 ± 44.6 (×103) for the GelMA/PEGDA and GelMA/PEGDA-CeO2 hybrid scaffolds with a CeO2 cont I confirm ent of 5% w/v, respectively.
Figure 10.
(A) Optical images of S. mutans adhered to GelMA/PEGDA and GelMA/PEGDA-CeO2 hydrogel scaffolds (CeO2 contents = 5% w/v) and (B) the numbers of colony-forming units.
This finding demonstrates that CeO2 nanoparticles synthesized in this study can effectively act as the antimicrobial agent by negligibly altering the biological and mechanical functions of GelMA/PEGDA hydrogel scaffolds [57,58,59]. More specifically, when the reasonably high CeO2 contents are employed, a fraction of CeO2 nanoparticles can be located at and near the surfaces of GelMA/PEGDA frameworks, and the fraction can increase due to the swelling and biodegradation of GelMA/PEGDA frameworks, thus offering long-term antimicrobial efficacy.
3.7. VP of Macroporous GelMA/PEGDA-CeO2 Hydrogel Scaffolds
To demonstrate the utility of GelMA/PEGDA-CeO2 hydrogel inks for VP, macroporous hydrogel scaffolds were manufactured by our custom-built VP printer. As the model, a honeycomb-inspired structure with a channel size (a) of 1 mm and wall thickness (b) of 0.5 mm was designed (Figure 11A). This unique macroporous structure can provide large surface areas for new tissue formation and pore sizes for a favorable VP process. Owing to the carefully optimized processing parameters for VP printing, including a layer thickness of 100 μm and UV illumination time of 3 s, allowed for manufacturing of macroporous GelMA/PEGDA-CeO2 hydrogel scaffolds even with the highest CeO2 content of 5% w/v, the manufactured hydrogel scaffolds showed highly controlled porous structures with a channel size of ~0.8 mm and wall thickness of ~0.6 mm. This finding suggests that our newly formulated GelMA/PEGDA-CeO2 hydrogel inks can be used to manufacture a variety of hydrogel scaffolds for tissue regeneration, particularly with antimicrobial efficacy using VP.

Figure 11.
(A) A unit cell used to manufacture honeycomb-inspired scaffolds and (B) optical image of the GelMA/PEGDA-CeO2 hydrogel scaffold manufactured by our VP printer. Letter ‘a’ represents the channel size, and letter ‘b’ represents wall thickness of honeycomb-inspired structure.
4. Conclusions
GelMa/PEGDA-CeO2 hydrogel inks were developed for vat photopolymerization of hydrogel scaffolds with antimicrobial efficacy. The CeO2 nanoparticles synthesized by the precipitation method could be uniformly blended with GelMA/PEGDA hydrogels owing to their round shape. In addition, the desired chemical structures (oxidation states of Ce3+ and Ce4+) and highly crystalline phases of CeO2 nanoparticles enabled GelMA/PEGDA-CeO2 hydrogel scaffolds (CeO2 content = 5% w/v) to have outstanding antimicrobial efficacy while maintaining reasonable compressive strengths and moduli, a high swelling ratio, and the desired biodegradation rate. In addition, hydrogel inks could be successfully utilized for manufacturing macroporous hydrogel scaffolds with tightly controlled porous structures by vat photopolymerization at 60 °C.
Author Contributions
Conceptualization, N.A.M., G.-N.K., and Y.-H.K.; methodology, N.A.M., G.-N.K., and Y.-H.K.; validation, G.-N.K.; investigation, N.A.M., G.-N.K., and Y.-H.K.; writing—original draft preparation, N.A.M., G.-N.K., and Y.-H.K.; writing—review and editing, G.-N.K. and Y.-H.K.; visualization, N.A.M., G.-N.K., and Y.-H.K.; supervision, Y.-H.K.; project administration, Y.-H.K.; funding acquisition, G.-N.K. and Y.-H.K. All authors have read and agreed to the published version of the manuscript.
Funding
This research was supported by the LINC 3.0 “Leaders in Industry-University Cooperation 3.0” project, supported by the Ministry of Education and National Research Foundation of Korea (Contract No. 1345370620, Development of photocurable hydrogel-based nanocomposite bioinks containing bioactive agents for wound healing), also by the Korea Medical Device Development Fund grant funded by the Korea government (the Ministry of Science and ICT, the Ministry of Trade, Industry and Energy, the Ministry of Health & Welfare, the Ministry of Food and Drug Safety) (Project Number: R2026615, RS-2020-KD000002), and BK21 FOUR (BrainKorea21 Fostering Outstanding Universities for Research) funded by the Ministry of Education and National Research Foundation of Korea (NRF).
Institutional Review Board Statement
Not applicable.
Informed Consent Statement
Not applicable.
Data Availability Statement
The original contributions presented in this study are included in the article. Further inquiries can be directed to the corresponding author.
Conflicts of Interest
The authors declare no conflicts of interest.
References
- El-Sherbiny, I.M.; Yacoub, M.H. Hydrogel scaffolds for tissue engineering: Progress and challenges. Glob. Cardiol. Sci. Pract. 2013, 3, 316–342. [Google Scholar] [CrossRef] [PubMed]
- Kesharwani, P.; Alexander, A.; Shukla, R.; Jain, S.; Bisht, A.; Kumari, K.; Verma, K.; Sharma, S. Tissue regeneration properties of hydrogels derived from biological macromolecules: A review. Int. J. Biol. Macromol. 2024, 271, 132280. [Google Scholar] [CrossRef] [PubMed]
- Yue, K.; Trujillo-de Santiago, G.; Alvarez, M.M.; Tamayol, A.; Annabi, B.; Khademhosseini, A. Synthesis, properties, and biomedical applications of gelatin methacryloyl (GelMA) hydrogels. Biomaterials 2015, 73, 254–271. [Google Scholar] [CrossRef] [PubMed]
- Bupphathong, S.; Quiroz, C.; Huang, W.; Chung, P.F.; Tao, H.Y.; Lin, C.H. Gelatin methacrylate hydrogel for tissue engineering applications—A review on material modifications. Pharmaceuticals 2022, 15, 171. [Google Scholar] [CrossRef]
- Moore, E.; West, J. Bioactive poly (ethylene glycol) acrylate hydrogels for regenerative engineering. Regenerat. Eng. Transl. Med. 2019, 5, 167–179. [Google Scholar] [CrossRef]
- O’Connell, C.D.; Zhang, B.; Onofrillo, C.; Duchi, S.; Blanchard, R.; Quigley, A.; Bourke, J.; Gambhir, S.; Kapsa, R.; Di Bella, C.; et al. Tailoring the mechanical properties of gelatin methacryloyl hydrogels through manipulation of the photocrosslinking conditions. Soft Matter 2018, 14, 2142–2151. [Google Scholar] [CrossRef]
- Best, J.P.; Cui, J.; Müllner, M.; Caruso, F. Tuning the mechanical properties of nanoporous hydrogel particles via polymer cross-linking. Langmuir 2013, 29, 9824–9831. [Google Scholar] [CrossRef]
- Karmmerer, E.; Melchels, F.P.W.; Holzapfel, B.M.; Meckel, T.; Hutmacher, D.W.; Loessner, D. Gelatine methacrylamide-based hydrogels: An alternative three-dimensional cancer cell culture system. Acta Biomater. 2014, 10, 2551–2562. [Google Scholar] [CrossRef]
- Li, J.; Wang, W.; Li, M.; Song, P.; Lei, H.; Gui, X.; Zhou, C.; Liu, L. Biomimetic methacrylated gelatin hydrogel loaded with bone marrow mesenchymal stem cells for bone tissue regeneration. Front. Bioeng. Biotechnol. 2021, 9, 770049. [Google Scholar] [CrossRef]
- Khalili, M.H.; Zhang, R.; Wilson, S.; Goel, S.; Impey, S.A.; Aria, A.I. Additive manufacturing and physicomechanical characteristics of PEGDA hydrogels: Recent advances and perspective for tissue engineering. Polymers 2023, 15, 2341. [Google Scholar] [CrossRef]
- Hamedi, E.; Vahedi, N.; Sigaroodi, F.; Parandakh, A.; Hosseinzadeh, S.; Zeinali, F.; Khani, M.M. Recent progress of bio-printed PEGDA-based bioinks for tissue regeneration. Polym. Adv. Technol. 2023, 34, 3505–3517. [Google Scholar] [CrossRef]
- Luo, Y.; Zhang, T.; Lin, X. 3D printed hydrogel scaffolds with macro pores and interconnected microchannel networks for tissue engineering vascularization. Chem. Eng. J. 2022, 430, 132926. [Google Scholar] [CrossRef]
- Tripathi, S.; Mandal, S.S.; Bauri, S.; Maiti, P. 3D bioprinting and its innovative approach for biomedical applications. MedComm (2020) 2022, 4, e194. [Google Scholar] [CrossRef]
- Klotz, B.J.; Gawlitta, D.; Rosenberg, A.J.W.P.; Malda, J.; Melchels, F.P.W. Gelatin-methacryloyl hydrogels: Towards biofabrication-based tissue repair. Trends Biotechnol. 2016, 34, 394–407. [Google Scholar] [CrossRef]
- Liu, T.; Weng, W.; Zhang, Y.; Sun, S.; Yang, H. Applications of gelatin methacryloyl (GelMA) hydrogels in microfluidic technique-assisted tissue engineering. Molecules 2020, 25, 5305. [Google Scholar] [CrossRef] [PubMed]
- Ghosh, R.N.; Thomas, J.; Vaidehi, B.R.; Devi, N.G.; Janardanan, A.; Namboothiri, P.K.; Peter, M. An insight into synthesis, properties and applications of gelatin methacryloyl hydrogel for 3D bioprinting. Mater. Adv. 2023, 4, 5496–5529. [Google Scholar] [CrossRef]
- Wang, H.; Wan, J.; Zhang, Z.; Hou, R. Recent advances on 3D-bioprinted gelatin methacrylate hydrogels for tissue engineering in wound healing: A review of current applications and future prospects. Int. Wound J. 2024, 21, e14533. [Google Scholar] [CrossRef]
- Pepelanova, I.; Kruppa, K.; Scheper, T.; Lavrentieva, A. Gelatin-methacryloyl (GelMA) hydrogels with defined degree of functionalization as a versatile toolkit for 3D cell culture and extrusion bioprinting. Bioengineering 2018, 5, 55. [Google Scholar] [CrossRef]
- Zhou, M.; Lee, B.H.; Tan, Y.J.; Tan, L.P. Microbial transglutaminase induced controlled crosslinking of gelatin methacryloyl to tailor rheological properties for 3D printing. Biofabrication 2019, 11, 025011. [Google Scholar] [CrossRef]
- Duan, J.; Cao, Y.; Shen, Z.; Cheng, Y.; Ma, Z.; Wang, L.; Zhang, Y.; An, Y.; Sang, S. 3D bioprinted GelMA/PEGDA hybrid scaffold for establishing an in vitro model of melanoma. J. Microbiol. Biotechnol. 2022, 32, 531–540. [Google Scholar] [CrossRef]
- Gu, Y.; Zou, Y.; Huang, Y.; Liang, R.; Wu, Y.; Hu, Y.; Hong, Y.; Zhang, X.; Toh, Y.C.; Ouyang, H.; et al. 3D-printed biomimetic scaffolds with precisely controlled and tunable structures guide cell migration and promote regeneration of osteochondral defect. Biofabrication 2024, 16, 015003. [Google Scholar] [CrossRef] [PubMed]
- Clauzel, J.; Colitti, N.; Combeau, M.; Labriji, W.; Robert, L.; Brilhault, A.; Cirillo, C.; Desmoulin, F.; Raymond-Letron, I.; Loubinoux, I. In vivo biocompatibility assessment of 3D printed bioresorbable polymers for brain tissue regeneration. A feasibility study. Regen. Ther. 2024, 26, 941–955. [Google Scholar] [CrossRef]
- Maeng, W.Y.; Lee, Y.; Chen, S.H.; Kim, K.S.; Sung, D.; Tseng, W.L.; Kim, G.N.; Koh, Y.H.; Hsueh, Y.Y.; Koo, J. 3D printed biodegradable hydrogel-based multichannel nerve conduits mimicking peripheral nerve fascicules. Mater. Today Bio 2025, 31, 101514. [Google Scholar] [CrossRef] [PubMed]
- Ye, W.; Li, H.; Yu, K.; Xie, C.; Wang, P.; Zheng, Y.; Zhang, P.; Xiu, J.; Yang, Y.; Zhang, F. 3D Printing of gelatin methacrylate-based nerve guidance conduits with multiple channels. Mater. Des. 2020, 192, 108757. [Google Scholar] [CrossRef]
- Liang, J.; Dijkstra, P.J.; Poot, A.A.; Grijpma, D.W. Hybrid hydrogels based on methacrylate-functionalized gelatin (GelMA) and synthetic polymers. Biomed. Mater. Devices 2023, 1, 191–201. [Google Scholar] [CrossRef]
- Yuan, M.; Liu, K.; Jiang, T.; Li, S.; Chen, J.; Wu, Z.; Li, W.; Tan, R.; Wei, W.; Yang, X.; et al. GelMA/PEGDA microneedles patch loaded with HUVECs-derived exosomes and tazarotene promote diabetic wound healing. J. Nanobiotechnol. 2022, 20, 147. [Google Scholar] [CrossRef]
- Wang, Y.; Ma, M.; Wang, J.; Zhang, W.; Lu, W.; Gao, Y.; Zhang, B.; Guo, Y. Development of a photo-crosslinking, biodegradable GelMA/PEGDA hydrogel for guided bone regeneration materials. Materials 2018, 11, 1345. [Google Scholar] [CrossRef]
- Mamaghani, K.R.; Naghib, S.M.; Zahedi, A.; Rahmanian, M.; Mozafari, M. GelMA/PEGDA containing graphene oxide as an IPN hydrogel with superior mechanical performance. Mater. Today Proc. 2018, 5, 15790–15799. [Google Scholar] [CrossRef]
- Gäbler, S.; Stampfl, J.; Koch, T.; Seidler, S.; Schüller, G.; Redl, H. Determination of the viscoelastic properties of hydrogels based on polyethylene glycol diacrylate (PEG-DA) and human articular cartilage. Int. J. Mater. Eng. Innov. 2009, 1, 3–20. [Google Scholar] [CrossRef]
- Annabi, N.; Nichol, J.W.; Zhong, X.; Ji, C.; Koshy, S.; Khademhosseini, A.; Dehghani, F. Controlling the porosity and microarchitecture of hydrogels for tissue engineering. Tissue Eng. Part B Rev. 2010, 16, 371–383. [Google Scholar] [CrossRef]
- Huang, L.; Guo, Z.; Yang, X.; Zhang, Y.; Liang, Y.; Chen, X.; Qiu, X.; Chen, X. Advancements in GelMA bioactive hydrogels: Strategies for infection control and bone tissue regeneration. Theranostics 2025, 15, 460–493. [Google Scholar] [CrossRef] [PubMed]
- Jahan, I.; George, E.; Saxena, N.; Sen, S. Silver-nanoparticle-entrapped soft gelMA gels as prospective scaffolds for wound healing. ACS Appl. Bio. Mater. 2019, 2, 1802–1814. [Google Scholar] [CrossRef]
- Dorterler, O.C.; Akgun, B.; Alper, M.; Ayhan, F. Improving antimicrobial properties of GelMA biocomposite hydrogels for regenerative endodontic treatment. Polymers 2024, 16, 1675. [Google Scholar] [CrossRef]
- Abdelmoneim, D.; Coates, D.; Porter, G.; Schmidlin, P.; Li, K.C.; Botter, S.; Lim, K.; Dunca, W. In vitro and in vivo investigation of antibacterial silver nanoparticles functionalized bone grafting substitutes. J. Biomed. Mater. Res. 2024, 112, 2042–2054. [Google Scholar] [CrossRef]
- Cheng, F.; Xu, L.; Zhang, X.; He, J.; Huang, Y.; Li, H. Generation of a photothermally responsive antimicrobial, bioadhesive gelatin methacryloyl (GelMA) based hydrogel through 3D printing for infectious wound healing. Int. J. Biol. Macromol. 2024, 260, 129372. [Google Scholar] [CrossRef] [PubMed]
- Han, Y.; Yin, Z.; Wang, Y.; Jiang, Y.; Chen, J.; Miao, Z.; He, F.; Cheng, R.; Tan, L.; Li, K. Photopolymerizable and antibacterial hydrogels loaded with metabolites from Lacticaseibacillus rhamnosus GG for infected wound healing. Biomacromolecules 2024, 25, 2587–2596. [Google Scholar] [CrossRef]
- Siebert, L.; Luna-Cerón, E.; García-Rivera, L.E.; Oh, J.; Jang, J.; Rosas-Gómez, D.A.; Pérez-Gómez, M.D.; Maschkowitz, G.; Fickenscher, H.; Oceguera-Cuevas, D.; et al. Light-controlled growth factors release on tetrapodal ZnO-incorporated 3D-printed hydrogels for developing smart wound scaffold. Adv. Funct. Mater. 2021, 31, 2007555. [Google Scholar] [CrossRef]
- Tao, B.; Lin, C.; Qin, X.; Yu, Y.; Guo, A.; Li, K.; Tian, H.; Yi, W.; Lei, D.; Chen, Y.; et al. Fabrication of gelatin-based and Zn2+-incorporated composite hydrogel for accelerated infected wound healing. Mater. Today Bio. 2022, 13, 100216. [Google Scholar] [CrossRef] [PubMed]
- Augustine, R.; Zahid, A.A.; Hasan, A.; Dalvi, Y.B.; Jacob, J. Cerium oxide nanoparticle-loaded gelatin methacryloyl hydrogel wound-healing patch with free radical scavenging activity. ACS Biomater. Sci. Eng. 2021, 7, 279–290. [Google Scholar] [CrossRef]
- Wang, R.; He, X.; Bai, J.; Su, S.; Zhou, R.; Gao, S.; Liu, H.; Zhou, F. Cerium oxide nanoparticles-reinforced GelMA hydrogel loading bone marrow stem cells with osteogenic and inflammatory regulatory capacity for bone defect repair. ACS Appl. Mater. Interfaces. 2024, 16, 67373–67384. [Google Scholar] [CrossRef]
- Kalaycıoglu, Z.; Kahya, N.; Adımcılar, V.; Kaygusuz, H.; Torlak, E.; Akın-Evingür, G.; Erim, F.B. Antibacterial nano cerium oxide/chitosan/cellulose acetate composite films as potential wound dressing. Eur. Polym. J. 2020, 133, 109777. [Google Scholar] [CrossRef]
- Kalantari, K.; Mostafavi, E.; Saleh, B.; Soltantabar, P.; Webster, T.J. Chitosan/PVA hydrogels incorporated with green synthesized cerium oxide nanoparticles for wound healing applications. Eur. Polym. J. 2020, 134, 109853. [Google Scholar] [CrossRef]
- Nosrati, H.; Heydari, M.; Khodaei, M. Cerium oxide nanoparticles: Synthesis methods and applications in wound healing. Mater. Today Bio 2023, 23, 100823. [Google Scholar] [CrossRef] [PubMed]
- Xue, Y.; Yang, F.; Wu, L.; Xia, D.; Liu, Y. CeO2 nanoparticles to promote wound healing: A Systematic review. Adv. Healthc. Mater. 2024, 13, e2302858. [Google Scholar] [CrossRef] [PubMed]
- Hu, Y.; Du, Y.; Jiang, H.; Jiang, G.S. Cerium promotes bone marrow stromal cells migration and osteogenic differentiation via smad1/5/8 signaling pathway. Int. J. Clin. Exp. Pathol. 2014, 7, 5369–5378. [Google Scholar]
- Farahmandjou, M.; Zarinkamar, M.; Firoozabadi, T.P. Synthesis of cerium oxide (CeO2) nanoparticles using simple co-precipitation method. Rev. Mex. Fis. 2016, 62, 496–499. [Google Scholar]
- Suresh, R.; Ponnuswamy, V.; Mariappan, R. Effect of annealing temperature on the microstructural, optical and electrical properties of CeO2 nanoparticles by chemical precipitation method. Appl. Surf. Sci. 2013, 273, 457–464. [Google Scholar] [CrossRef]
- Brady, G.A.; Halloran, J.W. Differential photo-calorimetry of photopolymerizable ceramic suspensions. J. Mater. Sci. 1998, 33, 4551–4560. [Google Scholar] [CrossRef]
- Patel, P.; Kansara, K.; Singh, R.; Shukla, R.K.; Singh, S.; Dhawan, A.; Kumar, A. Cellular internalization and antioxidant activity of cerium oxide nanoparticles in human monocytic leukemia cells. Int. J. Nanomed. 2018, 13, 39–41. [Google Scholar] [CrossRef]
- Tavarez-Martínez, G.M.; Onofre-Bustamante, E.; De La Cruz-Terrazas, E.C.; Escudero-Rincón, M.L.; Domínguez-Crespo, M.A. Evaluation of TiO2/CeO2 coating on Ti6Al4V alloy in PBS physiological medium using conventional and near field electrochemical techniques. Appl. Surf. Sci. 2019, 494, 1109–1118. [Google Scholar] [CrossRef]
- Bortamuly, R.; Konwar, G.; Boruah, P.K.; Das, M.R.; Mahanta, D.; Saikia, P. CeO2-PANI-HCl and CeO2-PANI-PTSA composites: Synthesis, characterization, and utilization as supercapacitor electrode materials. Ionics 2020, 26, 5747–5756. [Google Scholar] [CrossRef]
- Zhang, H.; Qiu, J.; Yan, B.; Liu, L.; Chen, D.; Liu, X. Regulation of Ce (III) / Ce (IV) ratio of cerium oxide for antibacterial application. iScience 2021, 24, 102226. [Google Scholar] [CrossRef]
- Jian, X.; Wang, H.; Jian, X.; Zou, Y.; Jiang, B.; Chen, C.; Guo, J.; Li, W.; Yu, B. A flexible adhesive hydrogel dressing of embedded structure with pro-angiogenesis activity for wound repair at moving parts inspired by commercial adhesive bandages. Mater. Today Adv. 2024, 21, 100452. [Google Scholar] [CrossRef]
- Todros, S.; Castilho, M.; Espino, D.M.; Pavan, P.G. Editorial: Mechanical behavior of hydrogels for soft tissue replacement and regeneration. Front. Bioeng. Biotechnol. 2023, 11, 1254076. [Google Scholar] [CrossRef]
- Van Damme, L.; Blondeel, P.; Van Vilerberghe, S. Injectable biomaterials as minimal invasive strategy towards soft tissue regeneration–an overview. J. Phys. Mater. 2021, 4, 022001. [Google Scholar] [CrossRef]
- Chanmugam, A.; Langemo, D.; Thomason, K.; Haan, J.; Altenburger, E.A.; Tippett, A.; Henderson, L.; Zortman, T.A. Relative temperature maximum in wound infection and inflammation as compared with a control subject using long-wave infrared thermography. Adv. Skin Wound Care 2017, 30, 406–414. [Google Scholar] [CrossRef] [PubMed]
- Farias, I.A.P.; Santos, C.C.L.; Sampaio, F.C. Antimicrobial activity of cerium oxide nanoparticles on opportunistic microorganisms: A systematic review. Biomed. Res. Int. 2018, 2018, 1923606. [Google Scholar] [CrossRef]
- Zamani, K.; Allah-Bakhshi, N.; Akhavan, F.; Yousefi, M.; Golmoradi, R.; Ramezani, M.; Bach, H.; Razavi, S.; Irajian, G.R.; Pakdin-Parizi, A.; et al. Antibacterial effect of cerium oxide nanoparticle against Pseudomonas aeruginosa. BMC Biotechnol. 2021, 21, 68. [Google Scholar] [CrossRef]
- Zhang, M.; Zhang, C.; Zhai, X.; Luo, F.; Du, Y.; Yan, C. Antibacterial mechanism and activity of cerium oxide nanoparticles. Sci. China Mater. 2019, 62, 1727–1739. [Google Scholar] [CrossRef]
Disclaimer/Publisher’s Note: The statements, opinions and data contained in all publications are solely those of the individual author(s) and contributor(s) and not of MDPI and/or the editor(s). MDPI and/or the editor(s) disclaim responsibility for any injury to people or property resulting from any ideas, methods, instructions or products referred to in the content. |
© 2025 by the authors. Licensee MDPI, Basel, Switzerland. This article is an open access article distributed under the terms and conditions of the Creative Commons Attribution (CC BY) license (https://creativecommons.org/licenses/by/4.0/).